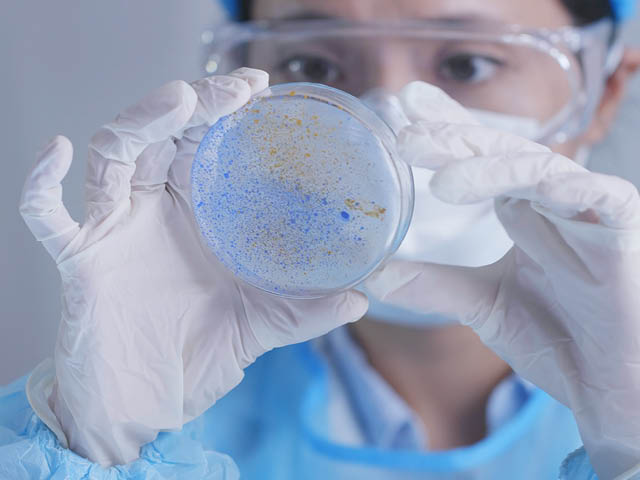

Product Storage Stability White Paper
Product Storage Stability White Paper Abstract
Storage stability testing is designed to confirm the product’s ability to maintain integrity throughout the intended shelf life, and to identify any storage limitations your product might have. The ultimate end-goal of this testing is to determine the appropriate expiration date for the product.
Some questions to consider:
- What type of stability study should I perform based on my active ingredient?
- What considerations should I make regarding packaging?
This paper provides insight into nominal ranges, testing requirements, stability study framework, and packaging.
Download Free Today
Find related Resources

Download for Free
Read our white paper to learn about some background on the main considerations for analytical method validation.
Click to DownloadThe Industries We Serve
Element offers a diverse, comprehensive suite of customized testing solutions and products for clients in the Antimicrobial, Food Production, Medical Device and Pharmaceutical industries.

Analytical Chemistry Testing
We offer our clients full product and analytical chemistry solutions. Our GLP and cGMP chemistry offerings include chemical characterization of active ingredients, testing of product-specific impurities, physical chemistry analysis and storage stability testing.

Microbiology Testing
Element offers a diverse array of microbiology testing services and can serve clients from early-stage antimicrobial product development and non-GLP screen testing all the way through GLP testing for submission.
Antimicrobial Testing
Antimicrobial testing performed in Element laboratories has supported the successful registration of thousands of antimicrobial products.
Sign Up for Free Resources
Visit Element's email subscription center to receive the latest industry news, technical whitepapers, case studies, webinars, and upcoming events.

